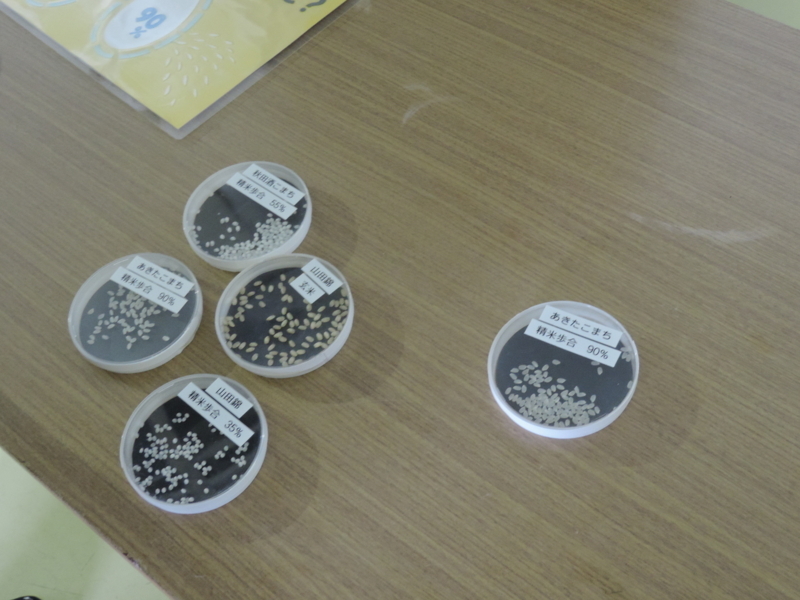
f:id:minato920:20180218205350j:plain f:id:minato920:20180218205350j:plain

振る舞い酒で身体を温めてから、酒蔵見学に入ります。エレベーターで最上階まで上がり、降りながら酒造りの工程を順に見ていくことになります。
酒米各種。精米歩合がだいぶ違います。35%の山田錦に至っては、外形が米に見えません。これを蒸して、麹に酵母を加えながら、もろみを作っていくわけです。

酒造用のタンク。昔なら大きな木の樽で、杜氏がその上に乗っていたのでしょうが、ここではタンクの上がまるごとフロアになっています。
タンクの高さは4メートル。タンク内では発酵が進んでいるので、フタはせず常に開けたまま。また内部は酸素がないというので、中に落ちたらおそらく一巻の終わりです。

仕込みを経てできたもろみが吊るされています。これで酒粕が分離され、原酒のできあがり。原酒の方がアルコールが強いので好きです(笑)

原酒は濾過、(生酒以外は)火入れされた上で貯蔵され、あとは瓶詰と出荷を待つばかり。ただ、貯蔵室の両横にある道具が何なのかは分かりません。聞けば良かったですね。

一通り酒造過程を見てから、お土産を貰います。酒粕に加えてワンカップもついてきました。

そしてお待ちかね、大試飲会!このために秋田まで来たのです。

大吟醸から新酒から、各種の酒がずらりと並んでいます。既に試飲目当ての人々が集まっていて、中にはおつまみまで持ち込んだ用意の良い人までいます。

集まったのは日本酒だけではありません。梅酒や秋田県産の野イチゴを使ったお酒というのもあります。そして日本酒の中には「解脱酒」という耳慣れないものを見つけました。

解脱酒は完熟して熟成滓が発生した酒だそうで、ご覧のとおり琥珀色。味も普通の日本酒とは違う感じで、モンゴルのチャツァルガナ(サジー)のワインに近いと言うべきか、って一般の人には伝わらない形容で済みません。ただ料理には幅広く合うと思いますよ。

一通り、いや二通りか三通りか試飲させていただいて外に出ると、雪がさらに勢いを増してきました。そんな中でチンドン屋さんが演奏をしているわけですが、本当に、本当にご苦労様です。テントの中で演奏できれば良いのにと思ったのですが、それはそれで美学に合わないんでしょうかね。
ともあれ、酒蔵見学の行程はこれで終了。秋田駅に戻ります。

最寄りのバス停に着く頃には、多少天気は持ち直しました。ただバス停付近の大雪が消えるはずもなく、標柱の足元は雪で埋もれています。
ま、もっと寒いところだと頭まで雪で覆われたり、春になって雪が溶けたらなくなってた、なんてこともあるんでしょうが。週の頭には高知でも雪が積もったのですが、あの程度で騒いですんませんでした、という気分です。
